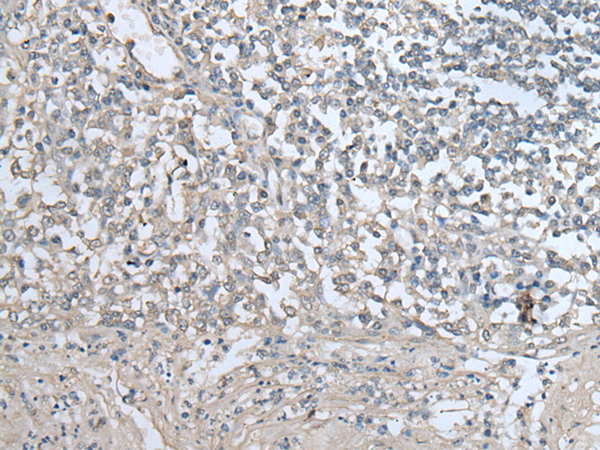

中文名稱: 兔抗UAP1多克隆抗體
|
Background: |
UAP1 belongs to the DPGP type 1 family. It converts UDP and GlcNAc-1-P into UDP-GlcNAc, and UDP and GalNAc-1-P into UDP-GalNAc. Isoform AGX1 has 2 to 3 times higher activity towards GalNAc-1-P, while isoform AGX2 has 8 times more activity towards GlcNAc-1-P. |
|
Applications: |
ELISA, WB, IHC |
|
Name of antibody: |
UAP1 |
|
Immunogen: |
Fusion protein of human UAP1 |
|
Full name: |
UDP-N-acetylglucosamine pyrophosphorylase 1 |
|
Synonyms: |
AGX; AGX1; AGX2; SPAG2 |
|
SwissProt: |
Q16222 |
|
ELISA Recommended dilution: |
5000-10000 |
|
IHC positive control: |
Human tonsil |
|
IHC Recommend dilution: |
25-100 |
|
WB Predicted band size: |
59 kDa |
|
WB Positive control: |
Human testis tissue lysate |
|
WB Recommended dilution: |
200-1000 |

購物車
幫助
021-54845833/15800441009
